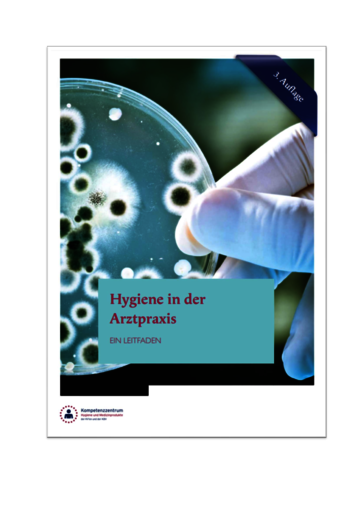

Hygieneleitfaden - Arztpraxis
Die Broschüre „Hygiene in der Arztpraxis. Ein Leitfaden“ (3. Auflage; 2023) hat sich wie die beiden Vorgängerversionen (2019, 2014) als kompaktes Unterstützungs- und Nachschlagewerk zu folgenden Themen etabliert:
- Rechtliche Rahmenbedingungen
- Arbeitsschutz und Arbeitssicherheit
- Hygienemanagement in der Arztpraxis
- Medizinprodukte
- Anforderungen an die Hygiene bei der Aufbereitung von Medizinprodukten
Ergänzung 08.2025: Aufgrund Änderungen verschiedener Rechtsgrundlagen entspricht die Broschüre an wenigen Stellen nicht mehr dem aktuellen Stand. Bis zur Aktualisierung der gesamten Ausgabe sind die wesentlichen Änderungen der einzelnen Kapitel auf einem „Einlegeblatt“ der Broschüre vorangestellt.
Für Fragen rund um Ihr Hygienemanagement steht Ihnen die Hygieneberatung der zuständigen Kassenärztlichen Vereinigung als Ansprechpartner unterstützend zur Seite.